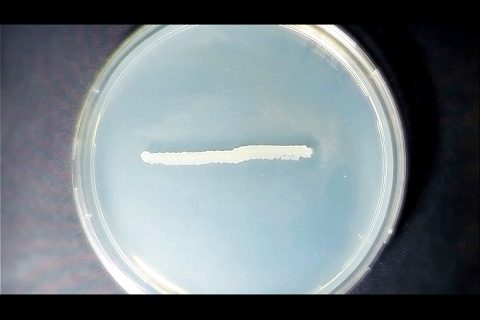

Бактерии. Новые возможности
Какую опасность и пользу несут бактерии? Подпишись на канал «Наука»: Чем больше мы проникаем в мир бактерий, тем больше удивительных свойств их узнаем. И тайны этого мира мы будем постигать еще очень и очень долго. Нам предстоит узнать, на что еще способны эти существа, какую опасность они могут представлять или какую пользу могут приносить человечеству.…